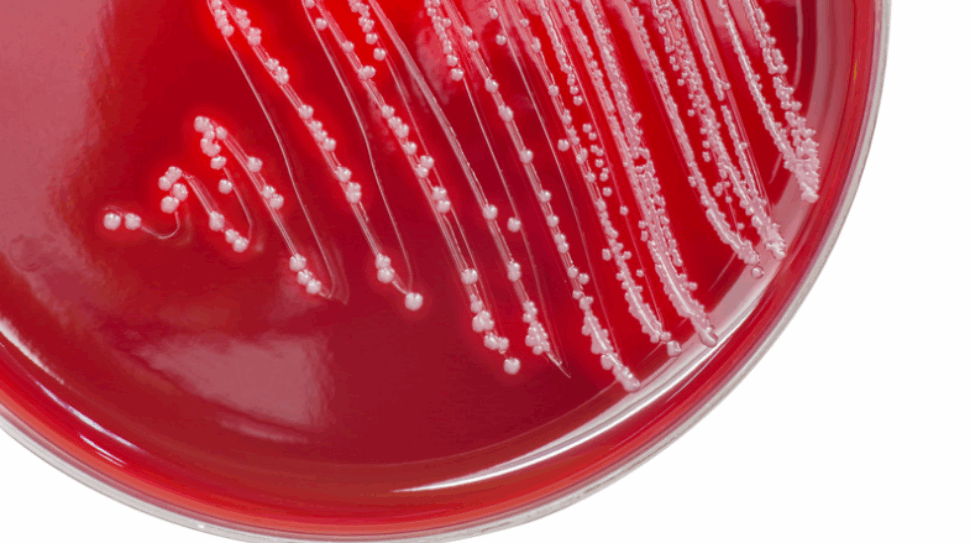
στρεπτόκοκκος

Απομακρυσμένη Παρακολούθηση Ασθενούς (Remote Monitoring)
Απομακρυσμένη Παρακολούθηση Ασθενούς, ονομάζεται η εξ αποστάσεως παρακολούθηση ασθενών με τη χρήση καινοτόμων τεχνολογιών. Τεχνολογίες Σύγχρονης Απομακρυσμένης Παρακολούθησης Η απομακρυσμένη παρακολούθηση σήμερα αξιοποιεί προηγμένα εργαλεία ό ...